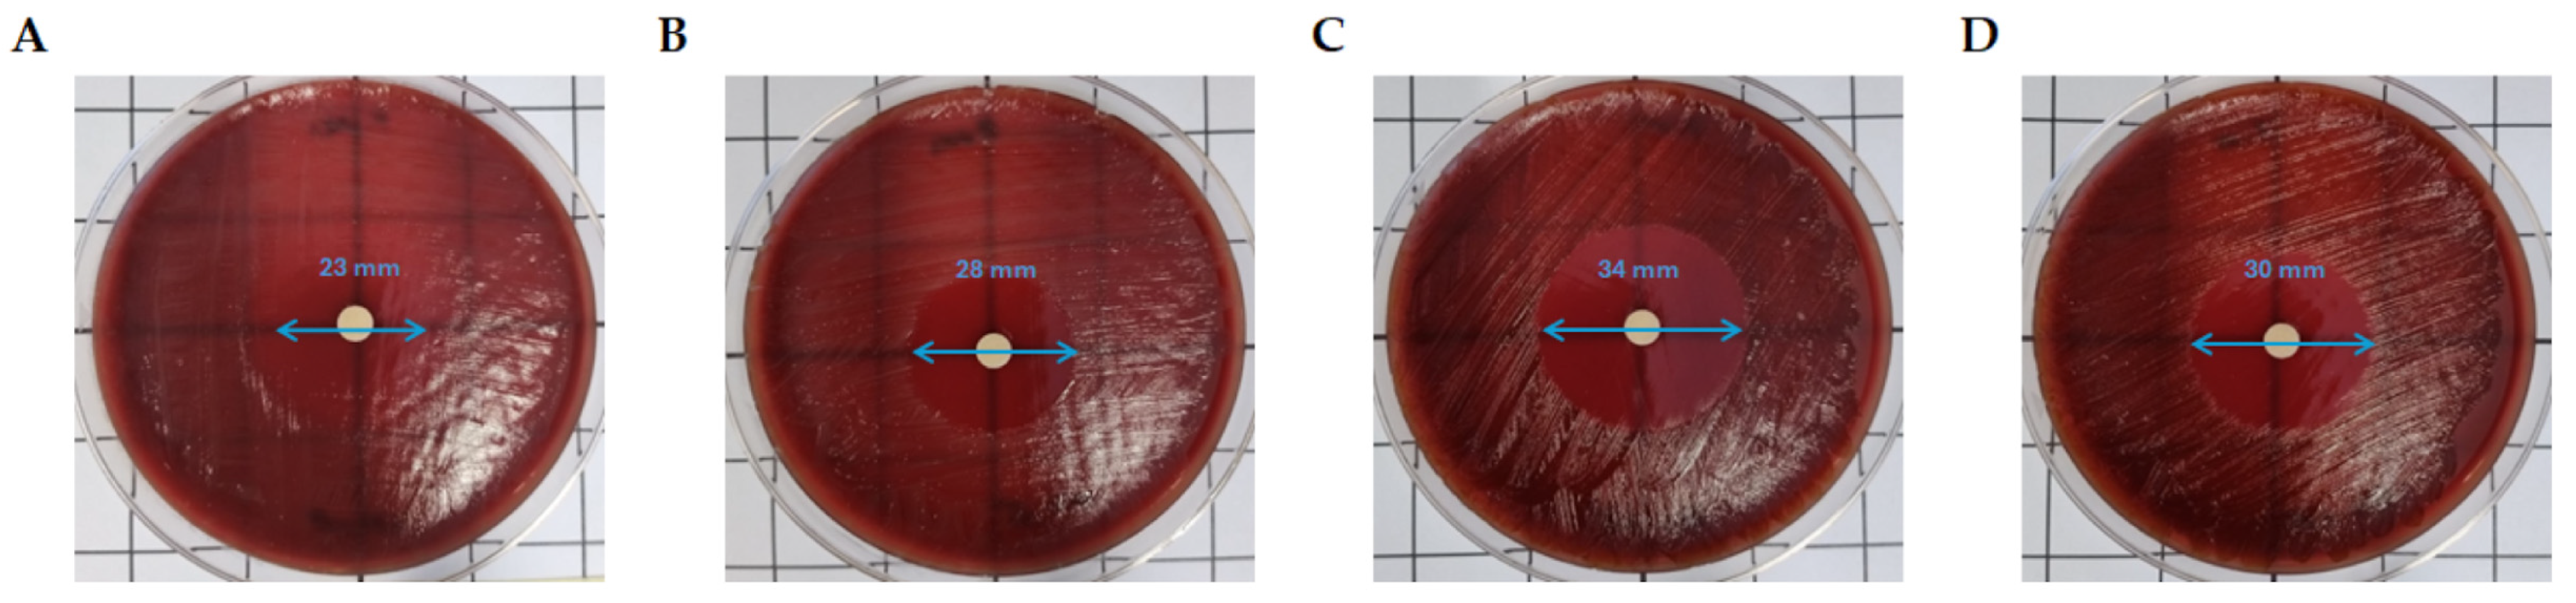

Advanced Platelet-Rich Fibrin (A-PRF) as Antibiotics Delivery System: In-Vitro Proof-of-Concept Study
Abstract
1. Introduction
2. Materials and Methods
2.1. Patient Selection
- -
- Young people (under the age of 18).
- -
- Volunteers with the willingness and ability to give their writing informed consent.
- -
- Absence of contraindications to blood sampling.
- -
- Use of systemic antibiotics in the past six months.
- -
- Drug therapy with non-steroidal anti-inflammatory drugs (NSAIDs) for a long time.
- -
- Antiplatelet and/or anticoagulant medication therapy.
- -
- Blood disorders (i.e., coagulopathies, thrombocytopenia).
- -
- Pregnancy or lactation.
2.2. Biochemical Tests
2.3. In Vitro Pharmacokinetic Analysis
2.4. Microbiological Analysis Method
2.5. Statistical Analysis
3. Results
3.1. Biochemical Analysis
3.2. Pharmacokinetic Analysis
3.3. Microbiological Analysis
4. Discussion
5. Conclusions
Author Contributions
Funding
Institutional Review Board Statement
Informed Consent Statement
Data Availability Statement
Conflicts of Interest
References
- Poveda Roda, R.; Bagan, J.V.; Sanchis Bielsa, J.M.; Carbonell Pastor, E. Antibiotic use in dental practice. A review. Med. Oral Patol. Oral Cir. Bucal. 2007, 12, E186–E192. [Google Scholar]
- Contaldo, M.; D’Ambrosio, F.; Ferraro, G.A.; Di Stasio, D.; Di Palo, M.P.; Serpico, R.; Simeone, M. Antibiotics in Dentistry: A Narrative Review of the Evidence beyond the Myth. Int. J. Environ. Res. Public Health 2023, 20, 6025. [Google Scholar] [CrossRef] [PubMed]
- Tewabe, A.; Abate, A.; Tamrie, M.; Seyfu, A.; Abdela Siraj, E. Targeted Drug Delivery—From Magic Bullet to Nanomedicine: Principles, Challenges, and Future Perspectives. J. Multidiscip. Healthc. 2021, 14, 1711–1724. [Google Scholar] [CrossRef] [PubMed]
- Mohammad, Z.; Zeeshan, A.; Faisal, S.; Md Wasim, H.; Suhail, A.; Sahar, I.; Mohd, S.; Nazma, K. Vesicular drug delivery system used for liver diseases. World J. Pharm. Sci. 2017, 5, 28–35. [Google Scholar]
- Jain, K.K. An Overview of Drug Delivery Systems. Methods Mol. Biol. 2020, 2059, 1–54. [Google Scholar] [PubMed]
- Wei, Y.; Deng, Y.; Ma, S.; Ran, M.; Jia, Y.; Meng, J.; Han, F.; Gou, J.; Yin, T.; He, H.; et al. Local drug delivery systems as therapeutic strategies against periodontitis: A systematic review. J. Control Release 2021, 333, 269–282. [Google Scholar] [CrossRef] [PubMed]
- Zhang, Y.; Jiang, R.; Lei, L.; Yang, Y.; Hu, T. Drug delivery systems for oral disease applications. J. Appl. Oral Sci. 2022, 30, e20210349. [Google Scholar] [CrossRef]
- Bayer, I.S. Advances in Fibrin-Based Materials in Wound Repair: A Review. Molecules 2022, 27, 4504. [Google Scholar] [CrossRef] [PubMed]
- Bielecki, T.; Dohan Ehrenfest, D.M. Platelet-rich plasma (PRP) and Platelet-Rich Fibrin (PRF): Surgical adjuvants, preparations for in situ regenerative medicine and tools for tissue engineering. Curr. Pharm. Biotechnol. 2012, 13, 1121–1130. [Google Scholar] [CrossRef] [PubMed]
- Del Fabbro, M.; Bortolin, M.; Taschieri, S. Is autologous platelet concentrate beneficial for post-extraction socket healing? A systematic review. Int. J. Oral Maxillofac. Surg. 2011, 40, 891–900. [Google Scholar] [CrossRef] [PubMed]
- Serafini, G.; Lopreiato, M.; Lollobrigida, M.; Lamazza, L.; Mazzucchi, G.; Fortunato, L.; Mariano, A.; Scotto d’Abusco, A.; Fontana, M.; De Biase, A. Platelet Rich Fibrin (PRF) and Its Related Products: Biomolecular Characterization of the Liquid Fibrinogen. J. Clin. Med. 2020, 9, 1099. [Google Scholar] [CrossRef] [PubMed]
- Ghanaati, S.; Booms, P.; Orlowska, A.; Kubesch, A.; Lorenz, J.; Rutkowski, J.; Landes, C.; Sader, R.; Kirkpatrick, C.; Choukroun, J. Advanced platelet-rich fibrin: A new concept for cell-based tissue engineering by means of inflammatory cells. J. Oral Implantol. 2014, 40, 679–689. [Google Scholar] [CrossRef] [PubMed]
- Lu, Y.; Hu, Q.; Jiang, C.; Gu, Z. Platelet for drug delivery. Curr. Opin. Biotechnol. 2019, 58, 81–91. [Google Scholar] [CrossRef] [PubMed]
- Spicer, P.P.; Mikos, A.G. Fibrin glue as a drug delivery system. J. Control Release 2010, 148, 49–55. [Google Scholar] [CrossRef] [PubMed]
- Jiskoot, W.; van Schie, R.M.; Carstens, M.G.; Schellekens, H. Immunological risk of injectable drug delivery systems. Pharm. Res. 2009, 26, 1303–1314. [Google Scholar] [CrossRef]
- Mestnik, M.J.; Feres, M.; Figueiredo, L.C.; Duarte, P.M.; Lira, E.A.; Faveri, M. Short-term benefits of the adjunctive use of metronidazole plus amoxicillin in the microbial profile and in the clinical parameters of subjects with generalized aggressive periodontitis. J. Clin. Periodontol. 2010, 37, 353–365. [Google Scholar] [CrossRef]
- Moeintaghavi, A.; Talebi-ardakani, M.R.; Haerian-ardakani, A.; Zandi, H.; Taghipour, S.; Fallahzadeh, H.; Pakzad, A.; Fahami, N. Adjunctive effects of systemic amoxicillin and metronidazole with scaling and root planing: A randomized, placebo controlled clinical trial. J. Contemp. Dent. Pract. 2007, 8, 51–59. [Google Scholar] [CrossRef] [PubMed]
- Akashi, M.; Kusumoto, J.; Takeda, D.; Shigeta, T.; Hasegawa, T.; Komori, T. A literature review of perioperative antibiotic administration in surgery for medication-related osteonecrosis of the jaw. Oral Maxillofac. Surg. 2018, 22, 369–378. [Google Scholar] [CrossRef]
- Miron, R.; Pinto, N.R.; Quirynen, M.; Ghanaati, S. Standardization of relative centrifugal forces in studies related to platelet-rich fibrin. J. Periodontol. 2019, 90, 817–820. [Google Scholar] [CrossRef] [PubMed]
- Kumar, P.; Ganure, A.L.; Subudhi, B.B.; Shukla, S. Design and Comparative Evaluation of In-vitro Drug Release, Pharmacokinetics and Gamma Scintigraphic Analysis of Controlled Release Tablets Using Novel pH Sensitive Starch and Modified Starch- acrylate Graft Copolymer Matrices. Iran. J. Pharm. Res. 2015, 14, 677–691. [Google Scholar]
- Askarizadeh, M.; Esfandiari, N.; Honarvar, B.; Sajadian, S.A.; Azdarpour, A. Kinetic Modeling to Explain the Release of Medicine from Drug Delivery Systems. ChemBioEng Rev. 2023, 10, 1006–1049. [Google Scholar] [CrossRef]
- Roe, D.E.; Finegold, S.M.; Citron, D.M.; Goldstein, E.J.; Wexler, H.M.; Rosenblatt, J.E.; Cox, M.E.; Jenkins, S.G.; Hecht, D.W. Multilaboratory comparison of growth characteristics for anaerobes, using 5 different agar media. Clin. Infect. Dis. 2002, 35, S36–S39. [Google Scholar] [CrossRef] [PubMed]
- Sharma, G.; Garg, N.; Hasan, S.; Shirodkar, S. Prevotella: An insight into its characteristics and associated virulence factors. Microb. Pathog. 2022, 169, 105673. [Google Scholar] [CrossRef]
- The Clinical and Laboratory Standards Institute (CLSI). Methods for Antimicrobial Susceptibility Testing of Anaerobic Bacteria. In Approved Standard M11-A7, 7th ed.; The Clinical and Laboratory Standards Institute (CLSI): Wayne, PA, USA, 2007. [Google Scholar]
- The Clinical and Laboratory Standards Institute (CLSI). Standards for Antimicrobial Susceptibility Testing. In CLSI Supplement M100, 30th ed.; The Clinical and Laboratory Standards Institute (CLSI): Wayne, PA, USA, 2020. [Google Scholar]
- The Clinical and Laboratory Standards Institute (CLSI). Methods for Antimicrobial Susceptibility Testing of Anaerobic Bacteria. In CLSI Standard M11, 9th ed.; The Clinical and Laboratory Standards Institute (CLSI): Wayne, PA, USA, 2018. [Google Scholar]
- The European Committee on Antimicrobial Susceptibility Testing. Breakpoint Tables for Interpretation of MICs and Zone Diameters. Version 14.0. 2024. Available online: http://www.eucast.org (accessed on 27 November 2024).
- Bavelaar, H.; Justesen, U.S.; Morris, T.E.; Anderson, B.; Copsey-Mawer, S.; Stubhaug, T.T.; Kahlmeter, G.; Matuschek, E. Development of a EUCAST disk diffusion method for the susceptibility testing of rapidly growing anaerobic bacteria using Fastidious Anaerobe Agar (FAA): A development study using Bacteroides species. Clin. Microbiol. Infect. 2021, 27, 1695.e1–1695.e6. [Google Scholar] [CrossRef]
- Matuschek, E.; Copsey-Mawer, S.; Petersson, S.; Åhman, J.; Morris, T.E.; Kahlmeter, G. The European committee on antimicrobial susceptibility testing disc diffusion susceptibility testing method for frequently isolated anaerobic bacteria. Clin. Microbiol. Infect. 2023, 29, 795.e1–795.e7. [Google Scholar] [CrossRef]
- Vyas, S.P.; Agrawal, U.; Sharma, R. Smart Polymeric Nano-Constructs. In Drug Delivery: Concept, Design and Therapeutic Applications, 1st ed.; Academic Press: Cambridge, MA, USA, 2022; pp. 65–107. [Google Scholar]
- Coelho, J.F.; Ferreira, P.C.; Alves, P.; Cordeiro, R.; Fonseca, A.C.; Góis, J.R.; Gil, M.H. Drug delivery systems: Advanced technologies potentially applicable in personalized treatments. EPMA J. 2010, 1, 164–209. [Google Scholar] [CrossRef] [PubMed]
- Levison, M.E.; Levison, J.H. Pharmacokinetics and pharmacodynamics of antibacterial agents. Infect. Dis. Clin. N. Am. 2009, 23, 791–815. [Google Scholar] [CrossRef] [PubMed]
- Rao, G.G.; Landersdorfer, C.B. Antibiotic pharmacokinetic/pharmacodynamic modelling: MIC, pharmacodynamic indices and beyond. Int. J. Antimicrob. Agents 2021, 58, 106368. [Google Scholar] [CrossRef]
- Nguyen, D.D.; Luo, L.J.; Yang, C.J.; Lai, J.Y. Highly Retina-Permeating and Long-Acting Resveratrol/Metformin Nanotherapeutics for Enhanced Treatment of Macular Degeneration. ACS Nano 2023, 17, 168–183. [Google Scholar] [CrossRef] [PubMed]
- An, X.; Yang, J.; Cui, X.; Zhao, J.; Jiang, C.; Tang, M.; Dong, Y.; Lin, L.; Li, H.; Wang, F. Advances in local drug delivery technologies for improved rheumatoid arthritis therapy. Adv. Drug Deliv. Rev. 2024, 209, 115325. [Google Scholar] [CrossRef] [PubMed]
- Miron, R.J.; Fujioka-Kobayashi, M.; Bishara, M.; Zhang, Y.; Hernandez, M.; Choukroun, J. Platelet-rich fibrin and soft tissue wound healing: A systematic review. Tissue Eng. B Rev. 2017, 23, 83–99. [Google Scholar] [CrossRef] [PubMed]
- Miron, R.J.; Fujioka-Kobayashi, M.; Sculean, A.; Zhang, Y. Optimization of platelet-rich fibrin. Periodontol. 2000 2024, 94, 79–91. [Google Scholar] [CrossRef] [PubMed]
- Polak, D.; Clemer-Shamai, N.; Shapira, L. Incorporating antibiotics into platelet-rich fibrin: A novel antibiotics slow-release biological device. J. Clin. Periodontol. 2019, 46, 241–247. [Google Scholar] [CrossRef]
- Bennardo, F.; Gallelli, L.; Palleria, C.; Colosimo, M.; Fortunato, L.; De Sarro, G.; Giudice, A. Can platelet-rich fibrin act as a natural carrier for antibiotics delivery? A proof-of-concept study for oral surgical procedures. BMC Oral Health 2023, 23, 134. [Google Scholar] [CrossRef] [PubMed]
- Chen, Y.; Huang, Z.; Tang, Z.; Huang, Y.; Huang, M.; Liu, H.; Ziebolz, D.; Schmalz, G.; Jia, B.; Zhao, J. More Than Just a Periodontal Pathogen -the Research Progress on Fusobacterium nucleatum. Front. Cell Infect. Microbiol. 2022, 12, 815318. [Google Scholar] [CrossRef] [PubMed]
- Könönen, E.; Fteita, D.; Gursoy, U.K.; Gursoy, M. Prevotella species as oral residents and infectious agents with potential impact on systemic conditions. J. Oral Microbiol. 2022, 14, 2079814. [Google Scholar] [CrossRef] [PubMed]
- Knafl, D.; Thalhammer, F.; Vossen, M.G. In-vitro release pharmacokinetics of amikacin, teicoplanin and polyhexanide in a platelet rich fibrin-layer (PRF)-a laboratory evaluation of a modern, autologous wound treatment. PLoS ONE 2017, 12, e0181090. [Google Scholar] [CrossRef] [PubMed]
- Rafiee, A.; Memarpour, M.; Taghvamanesh, S.; Karami, F.; Karami, S.; Morowvat, M.H. Drug Delivery Assessment of a Novel Triple Antibiotic-Eluting Injectable Platelet-Rich Fibrin Scaffold: An In Vitro Study. Curr. Pharm. Biotechnol. 2021, 22, 380–388. [Google Scholar] [PubMed]
- Siawasch, S.A.M.; Andrade, C.; Castro, A.B.; Teughels, W.; Temmerman, A.; Quirynen, M. Impact of local and systemic antimicrobials on leukocyte- and platelet rich fibrin: An in vitro study. Sci. Rep. 2022, 12, 2710. [Google Scholar] [CrossRef] [PubMed]
- TOKU-E Antibiotic Solubility Data Table. Available online: https://toku-e.com/solubility-data-resource/ (accessed on 19 December 2024).

| Model | Equation | Terms Used in Equation |
|---|---|---|
| Zero order | Q0 − Qt = K0t | Qt = quantity of drug released at time t; Q0 = initial amount of drug in solution; K = kinetic constants; t = time. |
| First order | Log (Q0) − Log (Qt) = Kt/2.303 | |
| Higuchi | Qt = KHT1/2 | |
| Hixon-Crowell | Q01/3 − Qt1/3 = KHCt |
| Antibiotic | Model | |||||||
|---|---|---|---|---|---|---|---|---|
| Zero Order | First Order | Higuchi | Hixson–Crowell | |||||
| R2 | K0 | R2 | K | R2 | KH | R2 | KHC | |
| Amoxicillin | 0.9415 | 0.3035 | 0.8965 | 0.0300 | 0.9939 | 5.6043 | 0.9416 | 0.0390 |
| Metronidazole | 0.9459 | 0.1696 | 0.8942 | 0.0318 | 0.9952 | 3.1554 | 0.9460 | 0.0392 |
| Agar Dilution MICs (ng/µL) | Disk Diffusion Zone of Inhibition (mm) a Using | |||||
|---|---|---|---|---|---|---|
| AMX b,c | MTZ b,d | AMX Disk (10 µg) e | MTZ Disk (5 µg) f | 10 µL AMX-Containing PBS Samples e | 10 µL MTZ-Containing PBS Samples f | |
| F. nucleatum AP05/97 | 0.064 | 0.125 | 44 | 35 | 23 | 28 |
| P. intermedia ATCC 25611 | 0.064 | 1.0 | 60 | 40 | 34 | 30 |
Disclaimer/Publisher’s Note: The statements, opinions and data contained in all publications are solely those of the individual author(s) and contributor(s) and not of MDPI and/or the editor(s). MDPI and/or the editor(s) disclaim responsibility for any injury to people or property resulting from any ideas, methods, instructions or products referred to in the content. |
© 2025 by the authors. Licensee MDPI, Basel, Switzerland. This article is an open access article distributed under the terms and conditions of the Creative Commons Attribution (CC BY) license (https://creativecommons.org/licenses/by/4.0/).
Share and Cite
Serafini, G.; Mariano, A.; Lollobrigida, M.; Lamazza, L.; Mazzucchi, G.; Spigaglia, P.; Barbanti, F.; Scotto d’Abusco, A.; De Biase, A. Advanced Platelet-Rich Fibrin (A-PRF) as Antibiotics Delivery System: In-Vitro Proof-of-Concept Study. Materials 2025, 18, 570. https://doi.org/10.3390/ma18030570
Serafini G, Mariano A, Lollobrigida M, Lamazza L, Mazzucchi G, Spigaglia P, Barbanti F, Scotto d’Abusco A, De Biase A. Advanced Platelet-Rich Fibrin (A-PRF) as Antibiotics Delivery System: In-Vitro Proof-of-Concept Study. Materials. 2025; 18(3):570. https://doi.org/10.3390/ma18030570
Chicago/Turabian StyleSerafini, Giorgio, Alessia Mariano, Marco Lollobrigida, Luca Lamazza, Giulia Mazzucchi, Patrizia Spigaglia, Fabrizio Barbanti, Anna Scotto d’Abusco, and Alberto De Biase. 2025. "Advanced Platelet-Rich Fibrin (A-PRF) as Antibiotics Delivery System: In-Vitro Proof-of-Concept Study" Materials 18, no. 3: 570. https://doi.org/10.3390/ma18030570
APA StyleSerafini, G., Mariano, A., Lollobrigida, M., Lamazza, L., Mazzucchi, G., Spigaglia, P., Barbanti, F., Scotto d’Abusco, A., & De Biase, A. (2025). Advanced Platelet-Rich Fibrin (A-PRF) as Antibiotics Delivery System: In-Vitro Proof-of-Concept Study. Materials, 18(3), 570. https://doi.org/10.3390/ma18030570

